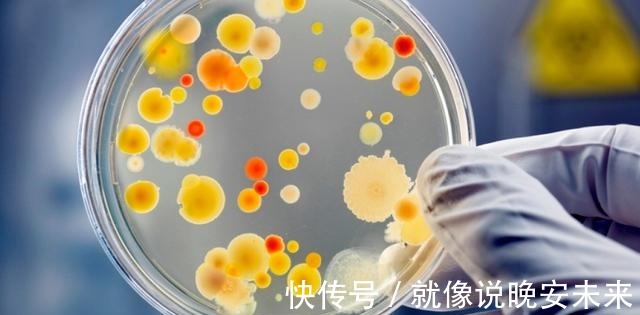
防腐剂 谈“成分”色变!护肤品中的防腐剂、酒精、香精,到底有多可怕!

防腐剂 谈“成分”色变!护肤品中的防腐剂、酒精、香精,到底有多可怕!
嗨,我是想要和你一起变美的考拉~护肤品成分的安全越来越受到大家的关注,很多姐妹在选购护肤品时,以0添加为要求,对带有无酒精、无香料、无防腐剂字样的产品非常执着。应这种产品选购需求,护肤品市场中出现了各种“无添加”护肤品,以至于一些传统的护肤品成分受到了不少人的排斥。

文章插图
事实上很多人在使用无添加护肤品后,皮肤状态似乎并没有得到更好的改善。无添加护肤品一定安全吗?护肤品中的防腐剂、酒精、香精等成分真的有这么可怕吗?今天我们就“零添加”护肤品详细聊一聊。

文章插图
无添加护肤品指护肤品中不添加对人体有危害的化学合成物质。我们国家对于无添加护肤品有明确的要求,不含七种成分的护肤品才能符合无添加产品定义。我们消费者对于“无添加”护肤品的理解,更多存在于不添加防腐剂层面。可含有防腐剂的护肤品,真的这么可怕吗?防腐剂简单来说起到了抑制微生物生长的作用。一般情况下,我们的护肤品使用时间在三个月左右,为什么它们会需要防腐剂呢?护肤品成分中,有很多供给微生物生长的营养物质,另外护肤品经常会与氧气接触,为部分微生物提供了生长环境。而护肤品被微生物、细菌污染,产品发生变质情况,与皮肤接触很容易导致皮肤发生应激反应,产生病变。

文章插图
除此之外,护肤品未开封保存时间通常在2-3年,要在如此长的时间里,保证护肤品成分活性不受到微生物侵袭,没有防腐剂是很难达到目的的。那么市面上标注无防腐剂的护肤品,是如何实现“保鲜”的呢?我们所提到的防腐剂对于皮肤潜在的危害性,通常是指传统防腐剂。随着科学技术发展,有很多新型防腐剂出现,它们不归属防腐剂目录,但同样能够发挥抑菌除臭的效果。
文章插图
另外部分产品会在配方体系和产品包装方面下功夫,让微生物、细菌无法生存或者构建无菌产品包装(比如安瓶产品),来达到防腐的目的。其实随着科技的进步,专业人士对于防腐剂研究越来越深,有安全隐患的防腐剂已经逐渐消失,取而代之的防腐剂,在刺激程度和用量上控制更为精准,对于皮肤几乎不会产生伤害。除超级敏感肌外,防腐剂对于我们的皮肤而言,并没有那么可怕。

文章插图
除防腐剂,酒精也是被大家“诟病”的成分之一。大家对于酒精的理解,多是刺激伤肤为主,不管护肤品中酒精含量高或低,都会被大家排斥。事实上,我们所说的酒精种种危害,多见于高浓度酒精。而护肤品中含有的酒精成分,一般不会超过5%。

文章插图
护肤品中酒精成分作用不同于医用酒精,它主要是作为溶剂使用。另外发挥促进功效成分渗透的作用。功效成分更深层作用于皮肤,这也是很多人在使用含有酒精成分的护肤品,皮肤出现不良反应的根本原因。一些护肤品添加酒精成分,是为了提高产品质地的透明度和产品成膜速度。对于油性皮肤而言,酒精成分有一定的溶解油脂,对抗皮肤油脂分泌过盛问题的功效。

文章插图
不过含有酒精成分的护肤品,也确实不适合部分肤质使用:比如干皮和敏感肌的姐妹,酒精在产品成分表中排名靠前的,这款护肤品就要谨慎选择。虽然酒精对于皮肤油脂分泌旺盛的油性肌肤比较友好,但是油敏皮肤质皮肤屏障结构出现损伤,对酒精的缓冲力弱,还需谨慎使用。另外对于酒精成分过敏的肤质,不论酒精浓度或含量多少,都应避免使用。
经验总结扩展阅读
- 女神“宽胯”的鲨鱼裤美女,擅长打造优雅靓丽风,魅力无穷
- 女神苏提达是冻龄女神,“花仙子”造型美出圈,高颜值碾压茜茜公主
- 下巴伊人小课堂 | 护肤:人人都有的“面霜”,怎么用才有效?
- 方法去角质有哪些方法,需要注意什么
- 穿衣搭配 辛芷蕾“野味儿”发型太阴森、好诡异?剪成高晓松真的只怪你。
- 穿衣搭配 迪丽热巴高马尾+西装杀,可御可甜!网友大呼“迪总娶我!”
- 进行悄悄告诉女人:护肤牢记4个“秘诀”,四十岁看起来也很年轻
- 棕色童瑶的私服搭配挺“普通”,棕色大衣配贝雷帽简约大气,挺显气质
- 姐妹“人间作精”欣欣子回归!开年演绎甜裤辣妹,真的美呆了!
- 手术 “专门针对男性的医美机构,需求量比我们想象还要大”
